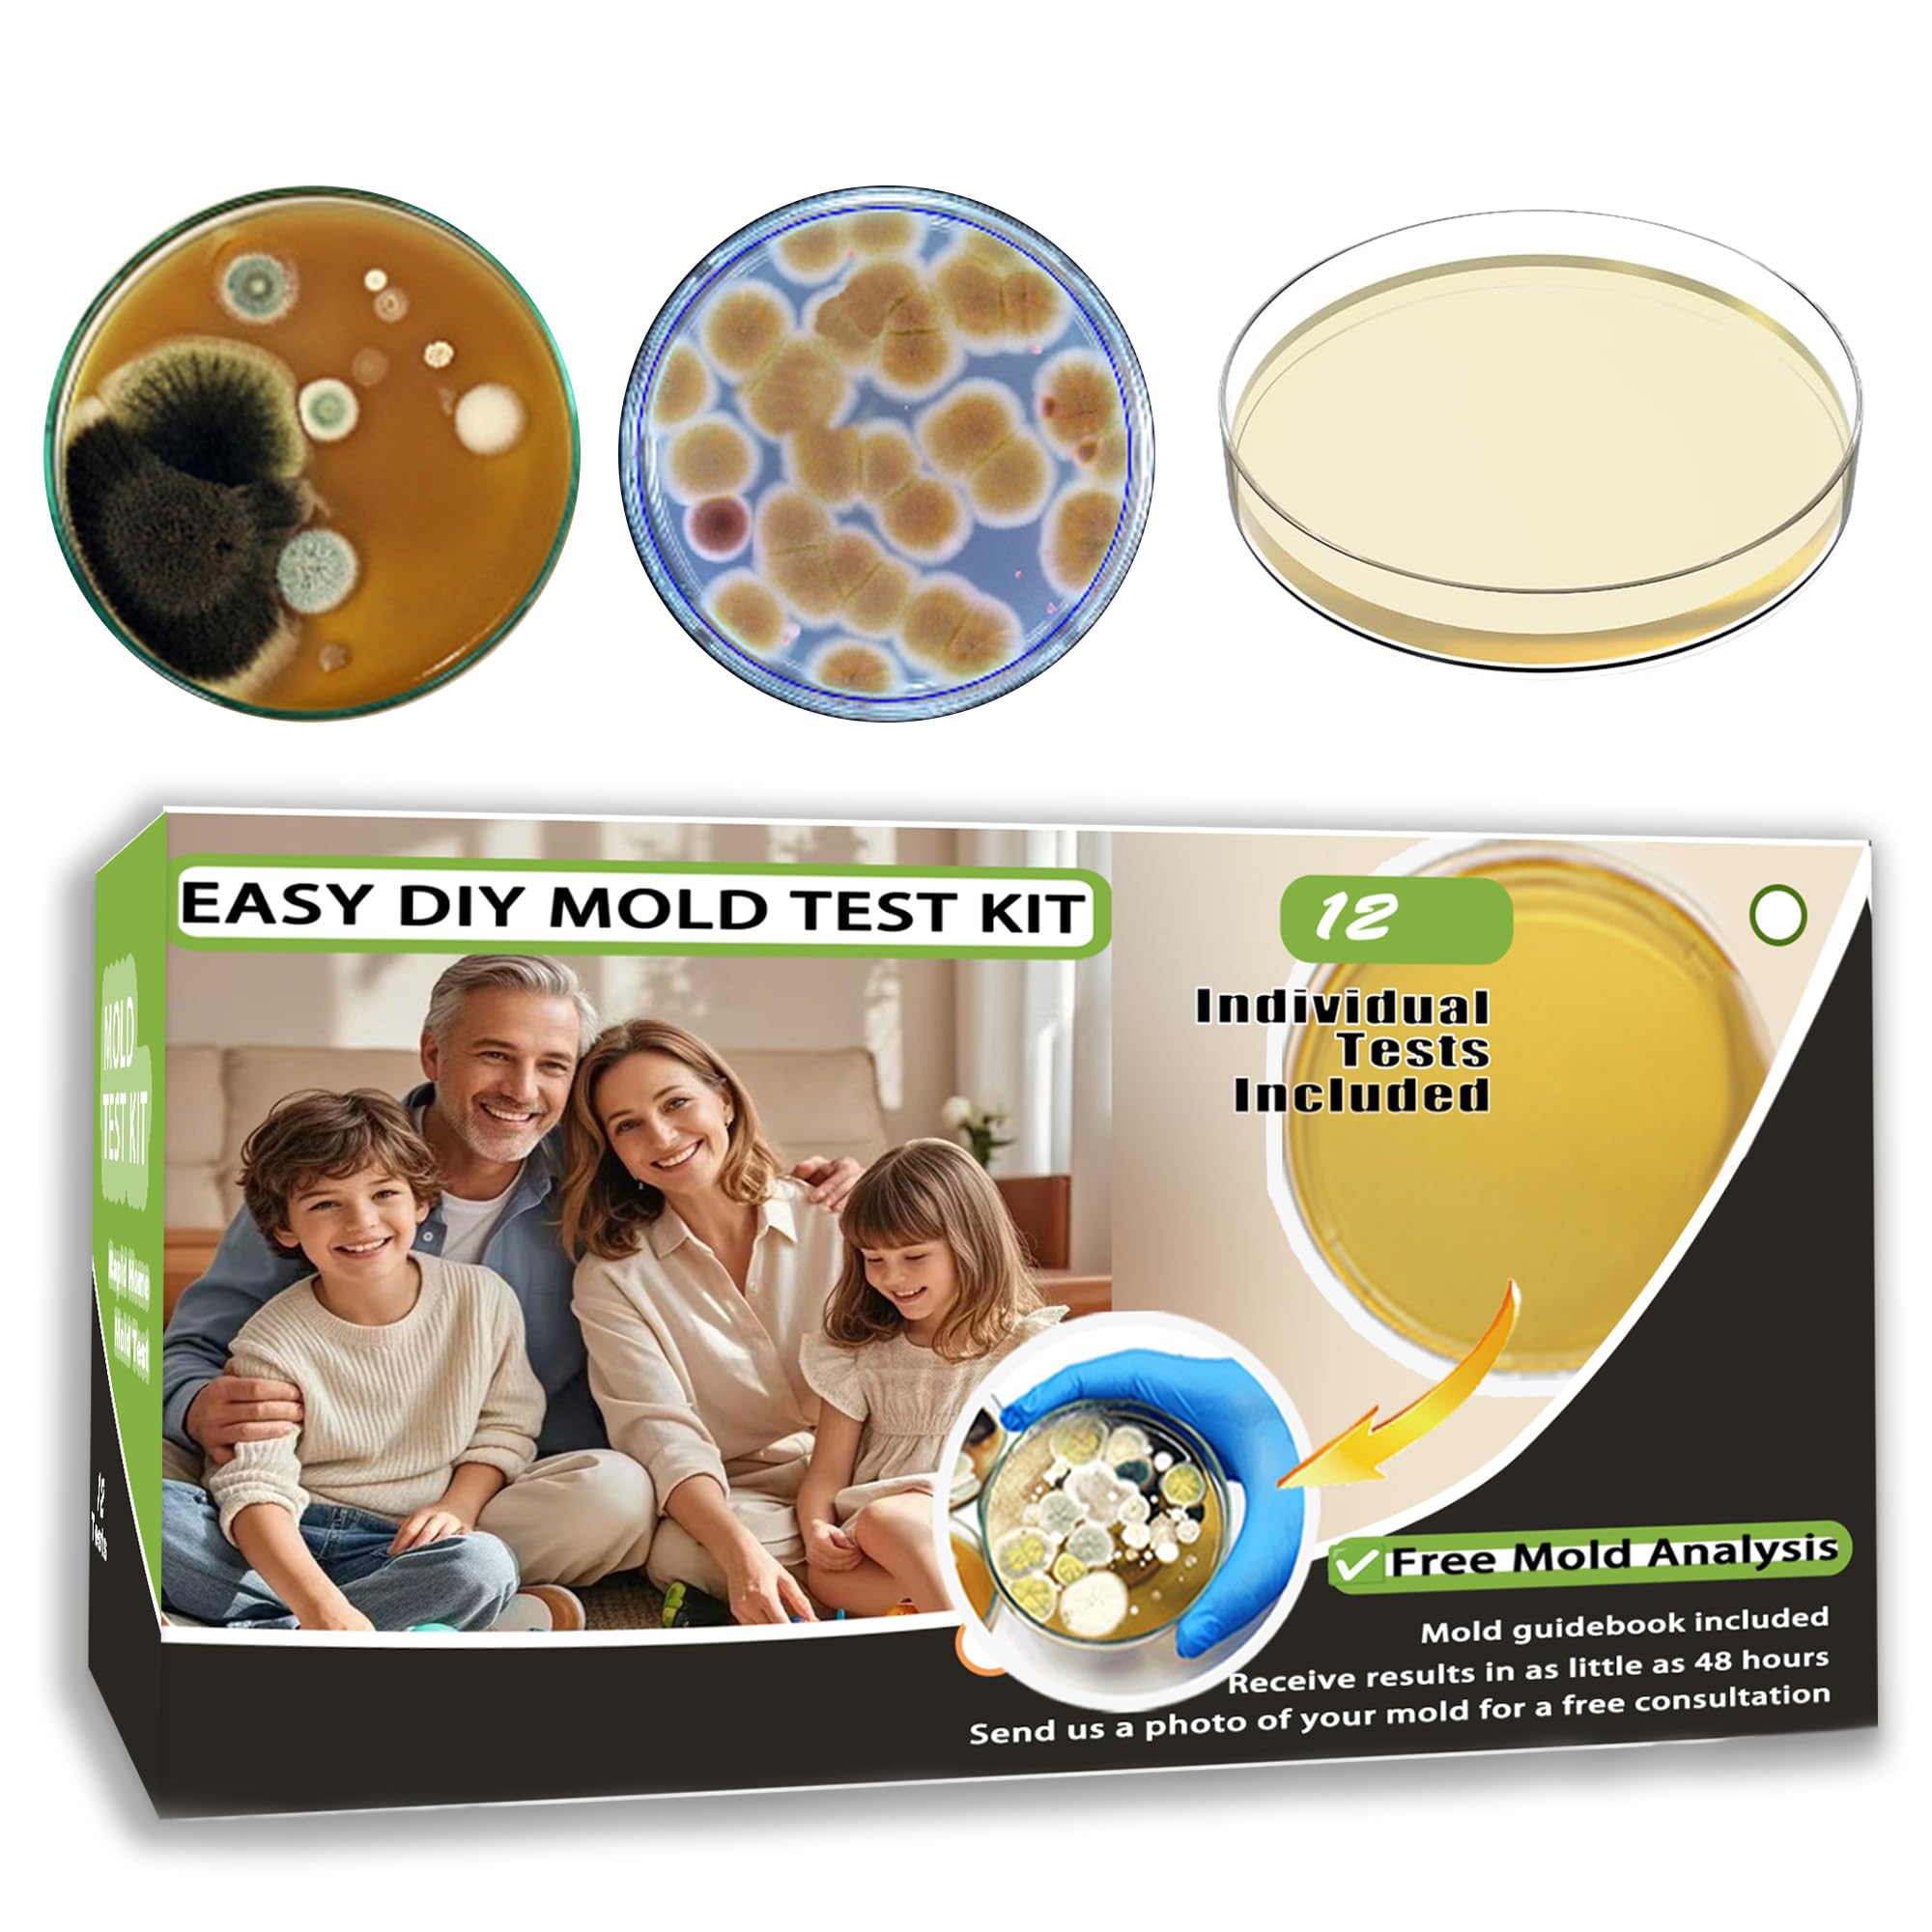
Mold Test Kit for Home 12 Simple Detection Tests, HVAC System, Home Surfaces, Indoor Air Quality Testing Kits, DIY Black Mold Detector at Home,

Eagle 30 Gallon Plastic Drum with Lid, Screw-On Lid, 28.3"x22.5", Lab Pack Drum Made of Durable, Lightweight HDPE, Withstands Weather and Chemicals,
$77.99
| Brand | Eagle |
| Merchant | Amazon |
| Category | Business & Industrial |
| Availability | In Stock |
| SKU | B003JFL6X8 |
| Color | Yellow |
| Size | 30 Gallon |
| Age Group | ADULT |
| Condition | NEW |
| Gender | UNISEX |
| Material | Alloy Steel |
About this item
Eagle 30 Gallon Plastic Drum with Lid, Screw-On Lid, 28.3"x22.5", Lab Pack Drum Made of Durable, Lightweight HDPE, Withstands Weather and Chemicals,
Designed for Regulatory Compliance - A plastic drum can help you meet regulations for the storage, transportation, and disposal of hazardous materials by selecting the lid based on the requirements for the material being handled Durable Construction - Made of blow-molded high-density polyethylene, this plastic barrel is durable, lightweight, and stands up to chemicals and weather, making it a great option for various storage needs High-Quality Material - This plastic barrel with lid is ideal for use with small undamaged bottles, cans, carboys, and 5-gallon pails of non-leaking hazardous materials, but not for use with free liquids Multipurpose Plastic Barrels - Though commonly used for hazardous material storage, these drums can also be used for bio-waste disposal, incineration, or as barrels for shipping Made in USA - Our top quality plastic barrels with lids are nestable for easy storage in smaller spaces while unused and have a tapered bottom for easy separation
| Brand | Eagle |
| Merchant | Amazon |
| Category | Business & Industrial |
| Availability | In Stock |
| SKU | B003JFL6X8 |
| Color | Yellow |
| Size | 30 Gallon |
| Age Group | ADULT |
| Condition | NEW |
| Gender | UNISEX |
| Material | Alloy Steel |
Similar Products
Compare with similar items

HZLZRZ 20 Ton Hydraulic Cylinder Jack wi... |

Scaphoid Pads, Small... |

SmartSign - U9-1462-NA "Caution - Hearin... |

The Strongest Available on Amazon 600 LB... |
|
|---|---|---|---|---|
| Price | $128.89 | $12.97 | $13.11 | $54.80 |
| Brand | HZLZRZ | Physical Therapy Aids | SmartSign | MAGNETO INC |
| Merchant | Amazon | Amazon | Amazon | Amazon |
| Availability | In Stock | In Stock Scarce | In Stock | In Stock |